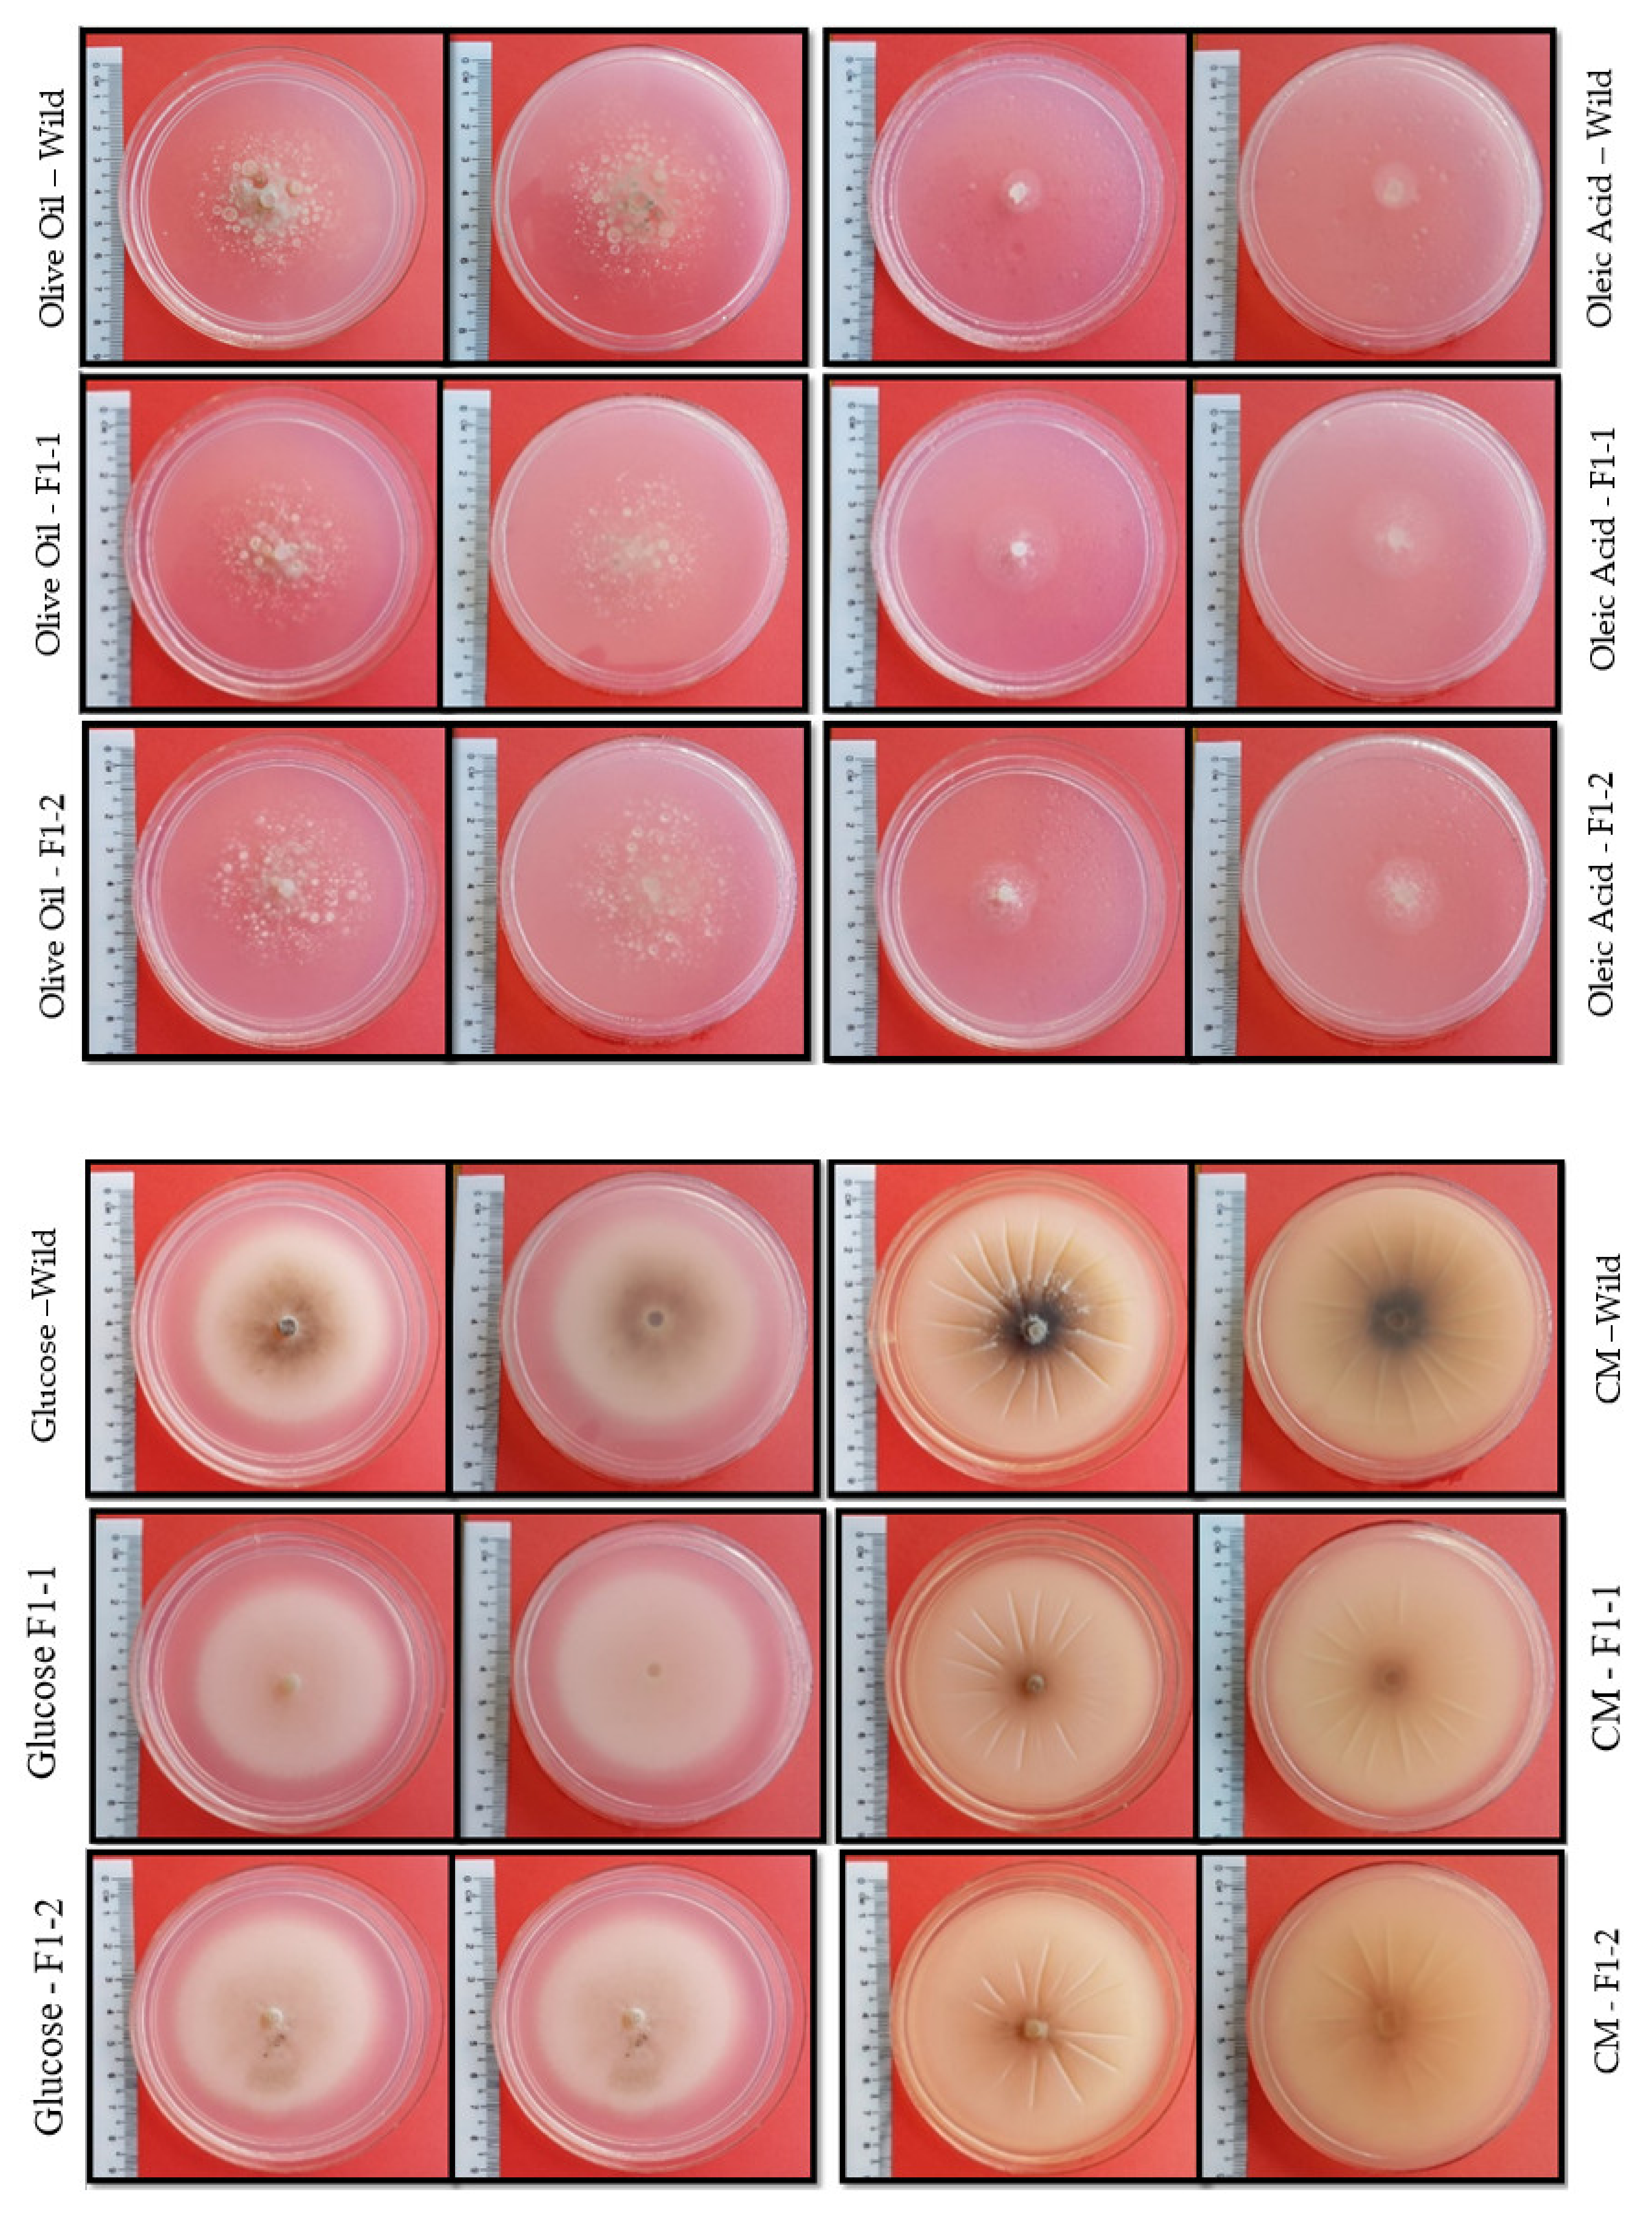

Fatty Acid Synthase Beta Dehydratase in the Lipid Biosynthesis Pathway Is Required for Conidiogenesis, Pigmentation and Appressorium Formation in Magnaporthe oryzae S6
Abstract
1. Introduction
2. Results and Discussion
2.1. Identification of FAS1 in M. Oryzae Strain S6
2.2. Generation of FAS1 Mutants
2.3. Carbon Source Utilization Altered in fas1 Mutants.
2.4. Mutants Display Reduced Pigmentation
2.5. Functional FAS1 Gene Needed for Conidiogenesis
2.6. FAS1 Enzyme Activity Is Essential for Appressorium Formation
2.7. FAS1 Mutant Exhibited Reduction in Machinery Connected to Fungal Pathogenicity
3. Materials and Methods
3.1. Fungal Strain Culture Condition
3.2. Fungal Genomic DNA Extraction
3.3. Identification and Sequencing of FAS1 Gene
3.4. Identification and Amplification of Flanking Region Fatty Acid Synthase
3.5. Homologous Double Crossover Method
3.6. Fungal Transformation and Screening
3.7. Protein Isolation, Concentration Determination and SDS Analysis
3.8. Conidiation, Appressorium Formation and Vegetative Growth Assays
3.9. Fatty Acid Synthase Beta Subunit Dehydratase Gene (FAS1) Assay Using ELISA Kit
3.10. FAS1 Gene Expression Analysis
3.11. Multiple Sequence Alignment and Phylogenetic Tree
3.12. Statistic Analysis Calculation
4. Conclusions
Supplementary Materials
Author Contributions
Funding
Acknowledgments
Conflicts of Interest
References
- Le Thanh, T.; Thumanu, K.; Wongkaew, S.; Boonkerd, N.; Teaumroong, N.; Phansak, P.; Buensanteai, N. Salicylic acid-induced accumulation of biochemical components associated with resistance against Xanthomonas oryzae pv. oryzae in rice. J. Plant Interact. 2017, 12, 108–120. [Google Scholar] [CrossRef]
- Aliyu, S.R.; Lin, L.; Chen, X.; Abdul, W.; Lin, Y.; Otieno, F.J.; Shabbir, A.; Batool, W.; Zhang, Y.; Tang, W.; et al. Disruption of putative short-chain acyl-CoA dehydrogenases compromised free radical scavenging, conidiogenesis, and pathogenesis of Magnaporthe oryzae. Fungal Genet. Biol. 2019, 127, 23–34. [Google Scholar] [CrossRef] [PubMed]
- Abbas, A.; Ansumali, S. Global potential of rice husk as a renewable feedstock for ethanol biofuel production. BioEnergy Res. 2010, 3, 328–334. [Google Scholar] [CrossRef]
- Chandrashekar, A.; Satyanarayana, K.V. Disease and pest resistance in grains of sorghum and millets. J. Cereal Sci. 2006, 44, 287–304. [Google Scholar] [CrossRef]
- Dean, R.A.; Talbot, N.J.; Ebbole, D.J.; Farman, M.L.; Mitchell, T.K.; Orbach, M.J.; Thon, M.; Kulkarni, R.; Xu, J.R.; Pan, H.; et al. The genome sequence of the rice blast fungus Magnaporthe grisea. Nature 2005, 434, 980. [Google Scholar] [CrossRef]
- Lemtukei, D.; Tamura, T.; Nguyen, Q.T.; Ueno, M. Inhibitory Activity of Burkholderia sp. Isolated from Soil in Gotsu City, Shimane, against Magnaporthe oryzae. Adv. Microbiol. 2017, 7, 137–148. [Google Scholar] [CrossRef][Green Version]
- Yan, J.Y.; Zhao, W.S.; Chen, Z.; Xing, Q.K.; Zhang, W.; Chethana, K.T.; Xue, M.F.; Xu, J.P.; Phillips, A.J.; Wang, Y.; et al. genome and transcriptome analyses reveal adaptations to opportunistic infections in woody plant degrading pathogens of Botryosphaeriaceae. DNA Res. 2017, 25, 87–102. [Google Scholar] [CrossRef]
- Filippi, M.C.; Prabhu, A.S. Integrated effect of host plant resistance and fungicidal seed treatment on rice blast control in Brazil. Plant Dis. 1997, 81, 351–355. [Google Scholar] [CrossRef][Green Version]
- Kubo, Y.; Takano, Y.; Endo, N.; Yasuda, N.; Tajima, S.; Furusawa, I. Cloning and structural analysis of the melanin biosynthesis gene SCD1 encoding scytalone dehydratase in Colletotrichum lagenarium. Appl. Environ. Microbiol. 1996, 62, 4340–4344. [Google Scholar] [CrossRef]
- Yan, X.; Que, Y.; Wang, H.; Wang, C.; Li, Y.; Yue, X.; Ma, Z.; Talbot, N.J.; Wang, Z. The MET13 methylenetetrahydrofolate reductase gene is essential for infection-related morphogenesis in the rice blast fungus Magnaporthe oryzae. PLoS ONE 2013, 8, e76914. [Google Scholar] [CrossRef]
- Li, G.; Zhou, X.; Kong, L.; Wang, Y.; Zhang, H.; Zhu, H.; Mitchell, T.K.; Dean, R.A.; Xu, J.R. MoSfl1 is important for virulence and heat tolerance in Magnaporthe oryzae. PLoS ONE 2011, 6, e19951. [Google Scholar] [CrossRef]
- Bhambra, G.K.; Wang, Z.Y.; Soanes, D.M.; Wakley, G.E.; Talbot, N.J. Peroxisomal carnitine acetyl transferase is required for elaboration of penetration hyphae during plant infection by Magnaporthe grisea. Mol. Microbiol. 2006, 61, 46–60. [Google Scholar] [CrossRef] [PubMed]
- Kim, K.S.; Lee, Y.H. Gene expression profiling during conidiation in the rice blast pathogen Magnaporthe oryzae. PLoS ONE 2012, 7, e43202. [Google Scholar] [CrossRef] [PubMed]
- Wang, Z.Y.; Soanes, D.M.; Kershaw, M.J.; Talbot, N.J. Functional analysis of lipid metabolism in Magnaporthe grisea reveals a requirement for peroxisomal fatty acid β-oxidation during appressorium-mediated plant infection. Mol. Plant-Microbe Interact. 2007, 20, 475–491. [Google Scholar] [CrossRef] [PubMed]
- Kawamura, C.; Moriwaki, J.; Kimura, N.; Fujita, Y.; Fuji, S.I.; Hirano, T.; Koizumi, S.; Tsuge, T. The melanin biosynthesis genes of Alternaria alternata can restore pathogenicity of the melanin-deficient mutants of Magnaporthe grisea. Mol. Plant-Microbe Interact. 1997, 10, 446–453. [Google Scholar] [CrossRef] [PubMed]
- Bin Yusof, M.T.; Kershaw, M.J.; Soanes, D.M.; Talbot, N.J. FAR1 and FAR2 regulate the expression of genes associated with lipid metabolism in the rice blast fungus Magnaporthe oryzae. PLoS ONE 2014, 9, e99760. [Google Scholar] [CrossRef]
- Weber, R.W.; Wakley, G.E.; Thines, E.; Talbot, N.J. The vacuole as central element of the lytic system and sink for lipid droplets in maturing appressoria of Magnaporthe grisea. Protoplasma 2001, 216, 101–112. [Google Scholar] [CrossRef]
- DeZwaan, T.M.; Carroll, A.M.; Valent, B.; Sweigard, J.A. Magnaporthe grisea pth11p is a novel plasma membrane protein that mediates appressorium differentiation in response to inductive substrate cues. Plant Cell 1999, 11, 2013–2030. [Google Scholar] [CrossRef]
- Deng, S.; Gu, Z.; Yang, N.; Li, L.; Yue, X.; Que, Y.; Sun, G.; Wang, Z.; Wang, J. Identification and characterization of the peroxin 1 gene MoPEX1 required for infection-related morphogenesis and pathogenicity in Magnaporthe oryzae. Sci. Rep. 2016, 6, 36292. [Google Scholar] [CrossRef]
- Bhadauria, V.; Banniza, S.; Vandenberg, A.; Selvaraj, G.; Wei, Y. Alanine: Glyoxylate aminotransferase 1 is required for mobilization and utilization of triglycerides during infection process of the rice blast pathogen, Magnaporthe oryzae. Plant Signal. Behav. 2012, 7, 1206–1208. [Google Scholar] [CrossRef][Green Version]
- Xu, J.R.; Hamer, J.E. MAP kinase and cAMP signaling regulate infection structure formation and pathogenic growth in the rice blast fungus Magnaporthe grisea. Genes Dev. 1996, 10, 2696–2706. [Google Scholar] [CrossRef] [PubMed]
- Zeng, X.Q.; Chen, G.Q.; Liu, X.H.; Dong, B.; Shi, H.B.; Lu, J.P.; Lin, F. Crosstalk between SNF1 pathway and the peroxisome-mediated lipid metabolism in Magnaporthe oryzae. PLoS ONE 2014, 9, e103124. [Google Scholar] [CrossRef] [PubMed]
- Thines, E.; Weber, R.W.; Talbot, N.J. MAP kinase and protein kinase A–dependent mobilization of triacylglycerol and glycogen during appressorium turgor generation by Magnaporthe grisea. Plant Cell 2000, 12, 1703–1718. [Google Scholar]
- Krishnan, H.K.; Nadarajah, K.K.; Kumar, I.S.; Sangappilai, V. Extraction and characterisation of proteins from a Malaysian Isolate of Magnaporthe grisea. Malays. J. Microbiol. 2018, 14, 519–532. [Google Scholar] [CrossRef]
- Fernandez, J.; Marroquin-Guzman, M.; Wilson, R.A. Evidence for a transketolase-mediated metabolic checkpoint governing biotrophic growth in rice cells by the blast fungus Magnaporthe oryzae. PLoS Pathog. 2014, 10, e1004354. [Google Scholar] [CrossRef]
- Foster, A.J.; Jenkinson, J.M.; Talbot, N.J. Trehalose synthesis and metabolism are required at different stages of plant infection by Magnaporthe grisea. EMBO J. 2003, 22, 225–235. [Google Scholar] [CrossRef]
- Johansson, P.; Mulinacci, B.; Koestler, C.; Vollrath, R.; Oesterhelt, D.; Grininger, M. Multimeric options for the auto-activation of the Saccharomyces cerevisiae FAS type I megasynthase. Structure 2009, 17, 1063–1074. [Google Scholar] [CrossRef][Green Version]
- Klug, L.; Daum, G. Yeast lipid metabolism at a glance. FEMS Yeast Res. 2014, 14, 369–388. [Google Scholar] [CrossRef]
- Wang, Z.Y.; Thornton, C.R.; Kershaw, M.J.; Debao, L.; Talbot, N.J. The glyoxylate cycle is required for temporal regulation of virulence by the plant pathogenic fungus Magnaporthe grisea. Mol. Microbiol. 2003, 47, 1601–1612. [Google Scholar] [CrossRef]
- Chirala, S.S. Coordinated regulation and inositol-mediated and fatty acid-mediated repression of fatty acid synthase genes in Saccharomyces cerevisiae. Proc. Natl. Acad. Sci. USA 1992, 89, 10232–10236. [Google Scholar] [CrossRef]
- Okagaki, L.H.; Nunes, C.C.; Sailsbery, J.; Clay, B.; Brown, D.; John, T.; Oh, Y.; Young, N.; Fitzgerald, M.; Haas, B.J. Genome sequences of three phytopathogenic species of the Magnaporthaceae family of fungi. G3 Genes Genomes Genet. 2015, 5, 2539–2545. [Google Scholar] [CrossRef]
- Gashaw, G.; Alemu, T.; Tesfaye, K. Morphological, physiological and biochemical studies on Pyricularia grisea isolates causing blast disease on finger millet in Ethiopia. J. Appl. Biosci. 2014, 74, 6059–6071. [Google Scholar] [CrossRef]
- Salimah, N.; Kuswinanti, T.; Nasruddin, A. Virulence diversity of rice blast Pyricularia oryzae Cavara. In Proceedings of the IOP Conference Series: Earth and Environmental Science, Universitas Muhammadiyah Buton, Indonesia, 3–4 August 2019; p. 012105. [Google Scholar]
- Islam, M.T.; Croll, D.; Gladieux, P.; Soanes, D.M.; Persoons, A.; Bhattacharjee, P.; Hossain, M.S.; Gupta, D.R.; Rahman, M.M.; Mahboob, M.G.; et al. Emergence of wheat blast in Bangladesh was caused by a South American lineage of Magnaporthe oryzae. BMC Biol. 2016, 14, 84. [Google Scholar] [CrossRef]
- Edgar, R.C. MUSCLE: Multiple sequence alignment with high accuracy and high throughput. Nucleic Acids Res. 2004, 32, 1792–1797. [Google Scholar] [CrossRef] [PubMed]
- Marchler-Bauer, A.; Bo, Y.; Han, L.; He, J.; Lanczycki, C.J.; Lu, S.; Chitsaz, F.; Derbyshire, M.K.; Geer, R.C.; Gonzales, N.R. CDD/SPARCLE: Functional classification of proteins via subfamily domain architectures. Nucleic Acids Res. 2016, 45, D200–D203. [Google Scholar] [CrossRef] [PubMed]
- Niwa, H.; Katayama, E.; Yanagida, M.; Morikawa, K. Cloning of the Fatty Acid Synthetase β Subunit from Fission Yeast, Coexpression with the α Subunit, and Purification of the Intact Multifunctional Enzyme Complex. Protein Expr. Purif. 1998, 13, 403–413. [Google Scholar] [CrossRef]
- Pidugu, L.S.; Maity, K.; Ramaswamy, K.; Surolia, N.; Suguna, K. Analysis of proteins with the’hot dog’fold: Prediction of function and identification of catalytic residues of hypothetical proteins. BMC Struct. Biol. 2009, 9, 37. [Google Scholar] [CrossRef]
- Dillon, S.C.; Bateman, A. The Hotdog fold: Wrapping up a superfamily of thioesterases and dehydratases. BMC Bioinform. 2004, 5, 109. [Google Scholar] [CrossRef]
- Leesong, M.; Henderson, B.S.; Gillig, J.R.; Schwab, J.M.; Smith, J.L. Structure of a dehydratase–isomerase from the bacterial pathway for biosynthesis of unsaturated fatty acids: Two catalytic activities in one active site. Structure 1996, 4, 253–264. [Google Scholar] [CrossRef]
- Schweizer, E.; Hofmann, J. Microbial type I fatty acid synthases (FAS): Major players in a network of cellular FAS systems. Microbiol. Mol. Biol. Rev. 2004, 68, 501–517. [Google Scholar] [CrossRef]
- Luo, J.; Zhang, N. Magnaporthiopsis, a new genus in Magnaporthaceae (Ascomycota). Mycologia 2013, 105, 1019–1029. [Google Scholar] [CrossRef] [PubMed]
- Zhang, Y.; Xu, K.; Yu, D.; Liu, Z.; Peng, C.; Li, X.; Zhang, J.; Dong, Y.; Zhang, Y.; Tian, P.; et al. The Highly Conserved Barley Powdery Mildew Effector BEC1019 Confers Susceptibility to Biotrophic and Necrotrophic Pathogens in Wheat. Int. J. Mol. Sci. 2019, 20, 4376. [Google Scholar] [CrossRef] [PubMed]
- Kawasaki-Tanaka, A.; Fukuta, Y. Genetic variation in resistance to blast disease (Pyricularia oryzae Cavara) in Japanese rice (Oryza sativa L.), as determined using a differential system. Breed. Sci. 2014, 64, 183–192. [Google Scholar] [CrossRef] [PubMed][Green Version]
- Sridhar, R.; Singh, U. Genetic and pathogenic diversity of the rice blast pathogen. In Major Fungal Diseases of Rice; Springer: Berlin/Heidelberg, Germany, 2001; pp. 1–7. [Google Scholar]
- Jones, D.T.; Taylor, W.R.; Thornton, J.M. The rapid generation of mutation data matrices from protein sequences. Bioinformatics 1992, 8, 275–282. [Google Scholar] [CrossRef]
- Felsenstein, J. Confidence-Limits on Phylogenies–A justification. Evolution 1985, 39, 783–791. [Google Scholar] [CrossRef]
- Kumar, S.; Stecher, G.; Li, M.; Knyaz, C.; Tamura, K. MEGA X: Molecular evolutionary genetics analysis across computing platforms. Mol. Biol. Evol. 2018, 35, 1547–1549. [Google Scholar] [CrossRef]
- Senanayake, I.C.; Crous, P.; Groenewald, J.; Maharachchikumbura, S.S.; Jeewon, R.; Phillips, A.J.; Bhat, J.; Perera, R.H.; Li, Q.R.; Li, W.J. Families of Diaporthales based on morphological and phylogenetic evidence. Stud. Mycol. 2017, 86, 217–296. [Google Scholar] [CrossRef]
- Blanco-Ulate, B.; Rolshausen, P.; Cantu, D. Draft genome sequence of the ascomycete Phaeoacremonium aleophilum strain UCR-PA7, a causal agent of the esca disease complex in grapevines. Genome Announc. 2013, 1, e00390-00313. [Google Scholar] [CrossRef]
- Challacombe, J.F.; Hesse, C.N.; Bramer, L.M.; McCue, L.A.; Lipton, M.; Purvine, S.; Nicora, C.; Porras-Alfaro, A.; Kuske, C.R. Genomes and secretomes of Ascomycota fungi reveal diverse functions in plant biomass decomposition and pathogenesis. BMC Genom. 2019, 20, 976. [Google Scholar] [CrossRef]
- Nourrisson, C.; Garcia-Hermoso, D.; Morio, F.; Kauffmann-Lacroix, C.; Berrette, N.; Bonhomme, J.; Poirier, P.; Lortholary, O.; Roblot, F.C.; Hoinard, D. Thermothelomyces thermophila human infections. Clin. Microbiol. Infect. 2017, 23, 338–341. [Google Scholar] [CrossRef]
- Havlik, D.; Brandt, U.; Bohle, K.; Fleißner, A. Establishment of Neurospora crassa as a host for heterologous protein production using a human antibody fragment as a model product. Microb. Cell Factories 2017, 16, 128. [Google Scholar] [CrossRef] [PubMed]
- Perfect, S.E.; Hughes, H.B.; O’Connell, R.J.; Green, J.R. Colletotrichum: A model genus for studies on pathology and fungal–plant interactions. Fungal Genet. Biol. 1999, 27, 186–198. [Google Scholar] [CrossRef] [PubMed]
- Fukada, F.; Kodama, S.; Nishiuchi, T.; Kajikawa, N.; Kubo, Y. Plant pathogenic fungi Colletotrichum and Magnaporthe share a common G1 phase monitoring strategy for proper appressorium development. New Phytol. 2019, 222, 1909–1923. [Google Scholar] [CrossRef]
- Teixeira, M.M.; de Almeida, L.G.; Kubitschek-Barreira, P.; Alves, F.L.; Kioshima, E.S.; Abadio, A.K.; Fernandes, L.; Derengowski, L.S.; Ferreira, K.S.; Souza, R.C.; et al. Comparative genomics of the major fungal agents of human and animal Sporotrichosis: Sporothrix schenckii and Sporothrix brasiliensis. BMC Genom. 2014, 15, 1–22. [Google Scholar] [CrossRef] [PubMed]
- Mora-Montes, H.M.; Dantas, A.d.S.; Trujillo-Esquivel, E.; de Souza Baptista, A.R.; Lopes-Bezerra, L.M. Current progress in the biology of members of the Sporothrix schenckii complex following the genomic era. FEMS Yeast Res. 2015, 15, 6. [Google Scholar] [CrossRef] [PubMed]
- Fehrer, J.; Réblová, M.; Bambasová, V.; Vohník, M. The root-symbiotic Rhizoscyphus ericae aggregate and Hyaloscypha (Leotiomycetes) are congeneric: Phylogenetic and experimental evidence. Stud. Mycol. 2019, 92, 195–225. [Google Scholar] [CrossRef]
- Priyatno, T.P.; Bakar, A.; Diba, F.; Kamaruddin, N.; Mahadi, N.M.; Murad, A.M.A. Inactivation of the catalytic subunit of cAMP-dependent protein kinase A causes delayed appressorium formation and reduced pathogenicity of Colletotrichum gloeosporioides. Sci. World J. 2012, 2012, 545784. [Google Scholar] [CrossRef]
- Yong, H.Y.; Bakar, F.D.A.; Illias, R.; Mahadi, N.; Murad, A.M.A. Cgl-SLT2 is required for appressorium formation, sporulation and pathogenicity in Colletotrichum gloeosporioide. Braz. J. Microbiol. 2013, 44, 1241–1250. [Google Scholar] [CrossRef]
- Gasteiger, E.; Hoogland, C.; Gattiker, A.; Wilkins, M.R.; Appel, R.D.; Bairoch, A. Protein identification and analysis tools on the ExPASy server. In The Proteomics Protocols Handbook; Springer: Berlin/Heidelberg, Germany, 2005; pp. 571–607. [Google Scholar]
- Dias, A.C.D.S.; Ruiz, N.; Couzinet-Mossion, A.; Bertrand, S.; Duflos, M.; Pouchus, Y.-F.; Barnathan, G.; Nazih, H.; Wielgosz-Collin, G. The marine-derived fungus Clonostachys rosea, source of a rare conjugated 4-Me-6E, 8E-hexadecadienoic acid reducing viability of MCF-7 breast cancer cells and gene expression of lipogenic enzymes. Mar. Drugs 2015, 13, 4934–4948. [Google Scholar] [CrossRef]
- Schönfeld, P.; Wojtczak, L. Short-and medium-chain fatty acids in energy metabolism: The cellular perspective. J. Lipid Res. 2016, 57, 943–954. [Google Scholar] [CrossRef]
- Kunau, W.H.; Dommes, V.; Schulz, H. β-Oxidation of fatty acids in mitochondria, peroxisomes, and bacteria: A century of continued progress. Prog. Lipid Res. 1995, 34, 267–342. [Google Scholar] [CrossRef]
- Ratnayake, W.N.; Galli, C. Fat and fatty acid terminology, methods of analysis and fat digestion and metabolism: A background review paper. Ann. Nutr. Metab. 2009, 55, 8–43. [Google Scholar] [CrossRef] [PubMed]
- Kuroki, M.; Shiga, Y.; Narukawa-Nara, M.; Arazoe, T.; Kamakura, T. Extremely low concentrations of acetic acid stimulate cell differentiation in rice blast fungus. Iscience 2020, 23, 100786. [Google Scholar] [CrossRef] [PubMed]
- Chen, Y.; Zhai, S.; Sun, Y.; Li, M.; Dong, Y.; Wang, X.; Zhang, H.; Zheng, X.; Wang, P.; Zhang, Z. MoTup1 is required for growth, conidiogenesis and pathogenicity of Magnaporthe oryzae. Mol. Plant Pathol. 2015, 16, 799–810. [Google Scholar] [CrossRef] [PubMed]
- Patkar, R.N.; Ramos-Pamplona, M.; Gupta, A.P.; Fan, Y.; Naqvi, N.I. Mitochondrial β-oxidation regulates organellar integrity and is necessary for conidial germination and invasive growth in Magnaporthe oryzae. Mol. Microbiol. 2012, 86, 1345–1363. [Google Scholar] [CrossRef] [PubMed]
- Zhong, K.; Li, X.; Le, X.; Kong, X.; Zhang, H.; Zheng, X.; Wang, P.; Zhang, Z. MoDnm1 dynamin mediating peroxisomal and mitochondrial fission in complex with MoFis1 and MoMdv1 is important for development of functional appressorium in Magnaporthe oryzae. PLoS Pathog. 2016, 12, e1005823. [Google Scholar] [CrossRef]
- Martínez-Rocha, A.L.; Roncero, M.I.G.; López-Ramirez, A.; Mariné, M.; Guarro, J.; Martínez-Cadena, G.; Di Pietro, A. Rho1 has distinct functions in morphogenesis, cell wall biosynthesis and virulence of Fusarium oxysporum. Cell. Microbiol. 2008, 10, 1339–1351. [Google Scholar] [CrossRef]
- Ramos-Pamplona, M.; Naqvi, N.I. Host invasion during rice-blast disease requires carnitine-dependent transport of peroxisomal acetyl-CoA. Mol. Microbiol. 2006, 61, 61–75. [Google Scholar] [CrossRef]
- Lipke, P.N.; Ovalle, R. Cell wall architecture in yeast: New structure and new challenges. J. Bacteriol. 1998, 180, 3735–3740. [Google Scholar] [CrossRef]
- Bulik, D.A.; Olczak, M.; Lucero, H.A.; Osmond, B.C.; Robbins, P.W.; Specht, C.A. Chitin synthesis in Saccharomyces cerevisiae in response to supplementation of growth medium with glucosamine and cell wall stress. Eukaryot. Cell 2003, 2, 886–900. [Google Scholar] [CrossRef]
- Li, M.; Liu, X.; Liu, Z.; Sun, Y.; Liu, M.; Wang, X.; Zhang, H.; Zheng, X.; Zhang, Z. Glycoside hydrolase MoGls2 controls asexual/sexual development, cell wall integrity and infectious growth in the rice blast fungus. PLoS ONE 2016, 11, e0162243. [Google Scholar] [CrossRef] [PubMed][Green Version]
- Wang, J.Y.; Li, L.; Chai, R.Y.; Qiu, H.P.; Zhang, Z.; Wang, Y.L.; Liu, X.H.; Lin, F.C.; Sun, G.C. Pex13 and Pex14, the key components of the peroxisomal docking complex, are required for peroxisome formation, host infection and pathogenicity-related morphogenesis in Magnaporthe oryzae. Virulence 2019, 10, 292–314. [Google Scholar] [CrossRef] [PubMed]
- Talbot, N.J. On the trail of a cereal killer: Exploring the biology of Magnaporthe grisea. Annu. Rev. Microbiol. 2003, 57, 177–202. [Google Scholar] [CrossRef] [PubMed]
- Kersten, S. Mechanisms of nutritional and hormonal regulation of lipogenesis. EMBO Rep. 2001, 2, 282–286. [Google Scholar] [CrossRef] [PubMed]
- Pfeifer, B.A.; Khosla, C. Biosynthesis of polyketides in heterologous hosts. Microbiol. Mol. Biol. Rev. 2001, 65, 106–118. [Google Scholar] [CrossRef]
- Breth, B.; Odenbach, D.; Yemelin, A.; Schlinck, N.; Schröder, M.; Bode, M.; Antelo, L.; Andresen, K.; Thines, E.; Foster, A.J. The role of the Tra1p transcription factor of Magnaporthe oryzae in spore adhesion and pathogenic development. Fungal Genet. Biol. 2013, 57, 11–22. [Google Scholar] [CrossRef]
- Bártová, V.; Bárta, J.; Brabcová, A.; Zdráhal, Z.; Horáčková, V. Analysis. Amino acid composition and nutritional value of four cultivated South American potato species. J. Food Compos. Anal. 2015, 40, 78–85. [Google Scholar] [CrossRef]
- Moat, A.G.; Ahmad, F.; Alexander, J.K.; Barnes, I.J. Alteration in the amino acid content of yeast during growth under various nutritional conditions. J. Bateriology 1969, 98, 573–578. [Google Scholar] [CrossRef]
- Mior, Z.A.; Tong, P.E.; Mohammadpourlima, M. Morphological and molecular characterizations of rice blast fungus, Magnaporthe oryzae. Pak. J. Agri. Sci 2017, 54, 765–772. [Google Scholar]
- Vanaraj, P.; Kandasamy, S.; Ambalavanan, S.; Ramalingam, R.; Sabariyappan, R. Variability in Pyricularia oryzae from different rice growing regions of Tamil Nadu, India. Afr. J. Microbiol. Res. 2013, 7, 3379–3388. [Google Scholar]
- Shi, Z.; Leung, H. Genetic analysis of sporulation in Magnaporthe grisea by chemical and insertional mutagenesis. MPMI-Mol. Plant Microbe Interact. 1995, 8, 949–959. [Google Scholar] [CrossRef]
- Bechinger, C.; Giebel, K.F.; Schnell, M.; Leiderer, P.; Deising, H.B.; Bastmeyer, M. Optical measurements of invasive forces exerted by appressoria of a plant pathogenic fungus. Science 1999, 285, 1896–1899. [Google Scholar] [CrossRef] [PubMed]
- Jeon, J.; Rho, H.; Kim, S.; Kim, K.S.; Lee, Y.H. Role of MoAND1-mediated nuclear positioning in morphogenesis and pathogenicity in the rice blast fungus, Magnaporthe oryzae. Fungal Genet. Biol. 2014, 69, 43–51. [Google Scholar] [CrossRef] [PubMed]
- Chen, Y.; Wu, X.; Li, C.; Zeng, Y.; Tan, X.; Zhang, D.; Liu, Y. MoPer1 is required for growth, conidiogenesis, and pathogenicity in Magnaporthe oryzae. Rice 2018, 11, 64. [Google Scholar] [CrossRef]
- Hynes, M.J.; Murray, S.L.; Duncan, A.; Khew, G.S.; Davis, M.A. Regulatory genes controlling fatty acid catabolism and peroxisomal functions in the filamentous fungus Aspergillus nidulans. Eukaryot. Cell 2006, 5, 794–805. [Google Scholar] [CrossRef]
- Muni, N.M.; Nadarajah, K. Morphological and molecular characterization of Magnaporthe oryzae (fungus) from infected rice leaf samples. In AIP Conference Proceedings; America Institute of Physics: College Park, MD, USA, 2014; pp. 756–760. [Google Scholar]
- Chee, K.; Tan, P.; Kalaivani, N. Characterisation of the barley oxalate oxidase gene and generation of rice transformant. Biotechnology 2012, 11, 263–271. [Google Scholar]
- Rodriguez, R.; Redman, R. Molecular Transformation and Genome Analysis of Colletotrichum; CAB Internatinal: Riverside, CA, USA, 1992. [Google Scholar]
- Bradford, M.M. A rapid and sensitive method for the quantitation of microgram quantities of protein utilizing the principle of protein-dye binding. Anal. Biochem. 1976, 72, 248–254. [Google Scholar] [CrossRef]
- Odenbach, D.; Breth, B.; Thines, E.; Weber, R.W.; Anke, H.; Foster, A.J. The transcription factor Con7p is a central regulator of infection-related morphogenesis in the rice blast fungus Magnaporthe grisea. Mol. Microbiol. 2007, 64, 293–307. [Google Scholar] [CrossRef]
- Livak, K.J.; Schmittgen, T.D. Analysis of relative gene expression data using real-time quantitative PCR and the 2− ΔΔCT method. Methods 2001, 25, 402–408. [Google Scholar] [CrossRef]
- Nadarajah, K.; Omar, N.S.; Rosli, M.M.; Shin Tze, O. Molecular characterization and screening for sheath blight resistance using Malaysian isolates of Rhizoctonia solani. BioMed Res. Int. 2014, 2014, 434257. [Google Scholar] [CrossRef]
- Motulsky, H.; Christopoulos, A. Fitting Models to Biological Data Using Linear and Nonlinear Regression: A Practical Guide to Curve Fitting; Oxford University Press: Oxford, UK, 2004. [Google Scholar]

| Media | CM (ng/mL) | Olive Oil (ng/mL) |
|---|---|---|
| Wildtype | 0.363 | 0.000 |
| fas1-1 | 0.000 | 0.000 |
| fas1-2 | 0.000 | 0.000 |
© 2020 by the authors. Licensee MDPI, Basel, Switzerland. This article is an open access article distributed under the terms and conditions of the Creative Commons Attribution (CC BY) license (http://creativecommons.org/licenses/by/4.0/).
Share and Cite
Sangappillai, V.; Nadarajah, K. Fatty Acid Synthase Beta Dehydratase in the Lipid Biosynthesis Pathway Is Required for Conidiogenesis, Pigmentation and Appressorium Formation in Magnaporthe oryzae S6. Int. J. Mol. Sci. 2020, 21, 7224. https://doi.org/10.3390/ijms21197224
Sangappillai V, Nadarajah K. Fatty Acid Synthase Beta Dehydratase in the Lipid Biosynthesis Pathway Is Required for Conidiogenesis, Pigmentation and Appressorium Formation in Magnaporthe oryzae S6. International Journal of Molecular Sciences. 2020; 21(19):7224. https://doi.org/10.3390/ijms21197224
Chicago/Turabian StyleSangappillai, Vaanee, and Kalaivani Nadarajah. 2020. "Fatty Acid Synthase Beta Dehydratase in the Lipid Biosynthesis Pathway Is Required for Conidiogenesis, Pigmentation and Appressorium Formation in Magnaporthe oryzae S6" International Journal of Molecular Sciences 21, no. 19: 7224. https://doi.org/10.3390/ijms21197224
APA StyleSangappillai, V., & Nadarajah, K. (2020). Fatty Acid Synthase Beta Dehydratase in the Lipid Biosynthesis Pathway Is Required for Conidiogenesis, Pigmentation and Appressorium Formation in Magnaporthe oryzae S6. International Journal of Molecular Sciences, 21(19), 7224. https://doi.org/10.3390/ijms21197224

